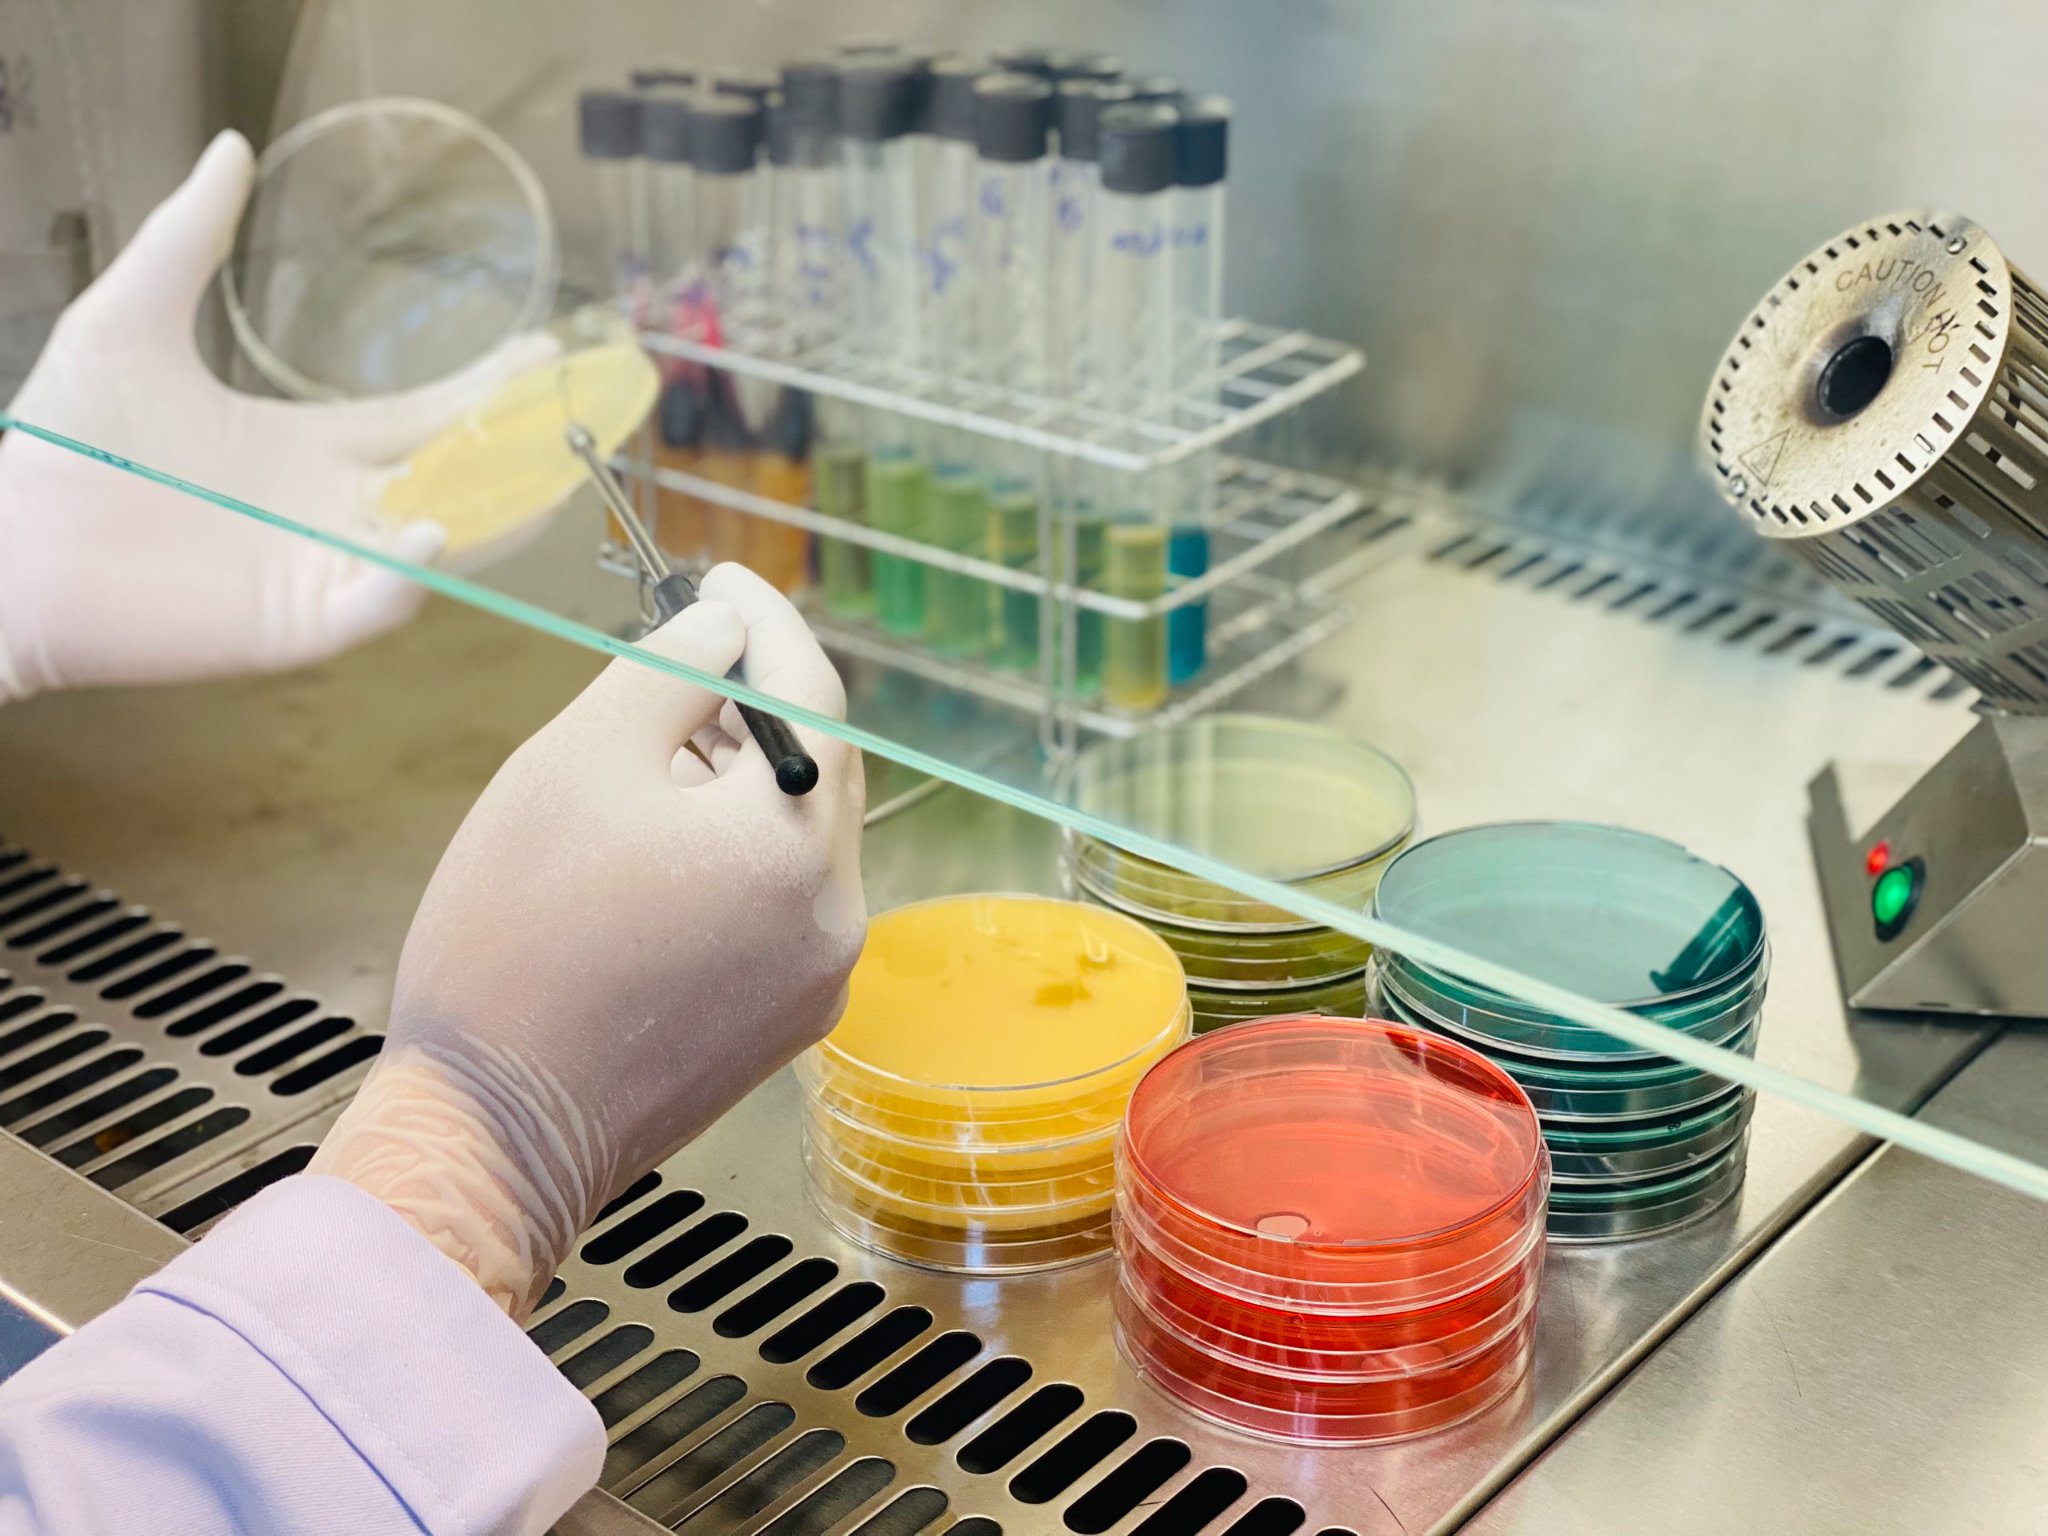

Đo lường chất lượng sản phẩm giúp nâng cao uy tín doanh nghiệp
(VietQ.vn) - Đo lường chất lượng sản phẩm là quá trình đánh giá các thuộc tính và đặc điểm của một sản phẩm để đảm bảo rằng nó đáp ứng các tiêu chuẩn và yêu cầu chất lượng đã được xác định trước.
Công ty Cổ phần Chăn nuôi C.P Việt Nam lên tiếng về thông tin bán sản phẩm kém chất lượng
Tiêu chuẩn RoHS: Từ 'hàng rào' thành 'cơ hội' cho doanh nghiệp điện tử
Đo lường chất lượng sản phẩm giúp nâng cao uy tín doanh nghiệp. (Ảnh minh họa).
Đo lường chất lượng sản phẩm giúp nâng cao uy tín doanh nghiệp. (Ảnh minh họa).
Trong bối cảnh cạnh tranh gay gắt, chất lượng sản phẩm hàng hóa, dịch vụ đóng vai trò then chốt đối với sự thành công và phát triển bền vững của mỗi doanh nghiệp. Đo lường chất lượng không chỉ giúp doanh nghiệp hiểu được mức độ thỏa mãn của khách hàng mà còn cung cấp thông tin cần thiết để cải tiến và tối ưu hóa các quy trình sản xuất và dịch vụ.
Cụ thể, đo lường chất lượng sản phẩm là quá trình đánh giá các thuộc tính và đặc điểm của một sản phẩm để đảm bảo rằng nó đáp ứng các tiêu chuẩn và yêu cầu chất lượng đã được xác định trước. Quá trình này không chỉ bao gồm việc kiểm tra các yếu tố kỹ thuật như kích thước, độ bền và tính năng, mà còn đánh giá tính thẩm mỹ, cảm nhận của người dùng cuối đối với sản phẩm.
Các chuyên gia cho biết, để thực hiện đo lường chất lượng sản phẩm, cần trải qua quy trình bao gồm 5 bước cơ bản: Thứ nhất là xác định tiêu chuẩn và yêu cầu chất lượng: Xác định rõ ràng các tiêu chuẩn chất lượng sản phẩm cần đạt được, dựa trên yêu cầu của khách hàng và các tiêu chuẩn ngành;
Thứ hai là thiết kế quy trình đo lường: Phát triển một quy trình đo lường chi tiết, xác định các phương pháp và công cụ sẽ được sử dụng để đánh giá chất lượng sản phẩm. Các phương pháp có thể bao gồm thử nghiệm, kiểm tra và đánh giá bên thứ ba;
Thứ ba là thực hiện đo lường: Tiến hành đo lường chất lượng dựa trên quy trình đã thiết kế. Điều này có thể bao gồm kiểm tra thường xuyên trong quá trình sản xuất và kiểm tra cuối cùng trước khi sản phẩm được giao cho khách hàng;
Thứ tư là phân tích dữ liệu và báo cáo: Tổng hợp và phân tích dữ liệu thu thập được từ quá trình đo lường để đánh giá mức độ đáp ứng tiêu chuẩn chất lượng. Báo cáo này nên nêu bật bất kỳ vấn đề nào cần được cải thiện;
Thứ năm là cải tiến dựa trên phản hồi: Dựa trên kết quả phân tích, xác định các biện pháp cải tiến chất lượng sản phẩm. Doanh nghiệp, tổ chức có thể áp dụng các chương trình cải tiến như Six Sigma hoặc Lean;… để giải quyết các vấn đề cụ thể và tối ưu hóa quy trình sản xuất.
Mặt khác, việc đo lường chất lượng sản phẩm mang lại rất nhiều lợi ích cho tổ chức, doanh nghiệp, như: Tăng cường sự hài lòng của khách hàng: Sản phẩm đạt chất lượng cao thường đáp ứng hoặc vượt quá kỳ vọng của khách hàng, từ đó tăng cường lòng trung thành và sự hài lòng của khách hàng;
Giảm chi phí: Phát hiện và giải quyết vấn đề chất lượng sớm trong quá trình sản xuất giúp giảm thiểu chi phí sửa chữa và chi phí liên quan đến việc xử lý sản phẩm lỗi hoặc khiếu nại của khách hàng;
Nâng cao hình ảnh thương hiệu: Một thương hiệu được biết đến với chất lượng sản phẩm cao sẽ thu hút nhiều khách hàng mới và tăng tính cạnh tranh trên thị trường;
Tuân thủ pháp lý và tiêu chuẩn: Đảm bảo sản phẩm tuân thủ quy định và tiêu chuẩn ngành có liên quan, giảm thiểu rủi ro pháp lý và đảm bảo an toàn cho người tiêu dùng;…
Mai Phương


















